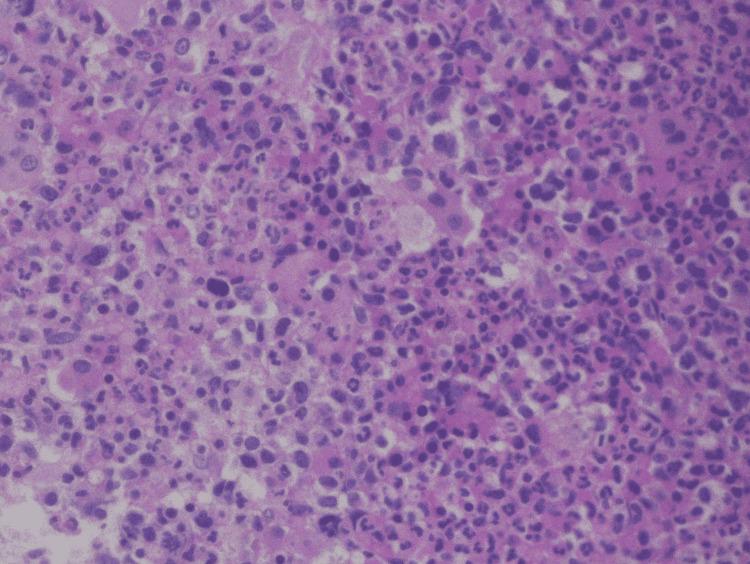
https://cdn.ncbi.nlm.nih.gov/pmc/blobs/2ff0/9356656/1032324ea472/cureus-0014-00000026619-i03.jpg

曲美替尼:它会是治疗非典型慢性髓性白血病的一种有前景的药物吗?
Trametinib: Could It Be a Promising Drug to Treat Atypical Chronic Myeloid Leukemia?
作者信息
Elsayed Marwa, Harry Stephanie, Nanua Suprana, Zaidi Shayaan, Habib Muhammad H, Raza Shahzad
机构信息
Internal Medicine, University of Missouri Kansas City School of Medicine, Kansas City, USA.
Hematology/Oncology, Saint Francis Cancer Center Warren Clinic, Tulsa, USA.
出版信息
Cureus. 2022 Jul 6;14(7):e26619. doi: 10.7759/cureus.26619. eCollection 2022 Jul.
Atypical chronic myeloid leukemia (aCML) is a rare disease that is currently classified under the myelodysplastic (MDS)/myeloproliferative neoplasm (MPN) disease spectrum. MDS/MPN diseases are characterized by the absence of the Philadelphia (Ph) chromosome and the overlap between bone marrow fibrosis and dysplastic features. The Ph chromosome, resulting from BCR-ABL1 translocation, helps to distinguish aCML from chronic myeloid leukemia (CML). The currently reported incidence of aCML is imprecise because aCML is diagnosed primarily based on morphological features and other unspecified laboratory findings, and there is an especially high chance of under-diagnosis of aCML and other MDS/MPN diseases. Recent advances in next-generation sequencing (NGS) have allowed a greater understanding of the nature of aCML, providing better opportunities to achieve higher diagnostic accuracy and for the use of more targeted treatment to achieve better outcomes. Herein, we present a case of a 68-year-old woman who came to our hospital complaining of shortness of breath, fatigue, and weakness, who was found to have significantly increased leukocytosis, hepatosplenomegaly, and was negative for the Ph chromosome. Further investigations with NGS revealed mutations in ASXL1, GATA2, NRAS, and SRSF2 but not CSF3R. In addition to this, peripheral smear and bone marrow aspiration findings were suggestive of aCML based on specific morphological findings. Since the patient was ineligible for a stem cell transplant (SCT), symptomatic treatment was started with cell transfusion; however, the patient continued to have symptomatic anemia that required multiple transfusions. A trial with trametinib, a mitogen-activated protein kinase kinase (MEK) inhibitor, was later started as a targeted therapy based on one of her genetic mutations. Interestingly, the patient's blood counts stabilized, she reported feeling better, and she did not need any blood transfusions for four consecutive months during treatment with trametinib. Unfortunately, our patient later died from sepsis resulting from secondary infections. In light of the significant advancements in NGS, clinicians should always consider utilizing it as a helpful tool to not only establish a rare diagnosis of aCML but also to offer the best available targeted therapy when applicable. This might alleviate the burden associated with the poor prognosis of aCML.
非典型慢性髓系白血病(aCML)是一种罕见疾病,目前归类于骨髓增生异常综合征(MDS)/骨髓增殖性肿瘤(MPN)疾病谱。MDS/MPN疾病的特征是不存在费城(Ph)染色体,以及骨髓纤维化和发育异常特征之间的重叠。由BCR-ABL1易位产生的Ph染色体有助于将aCML与慢性髓系白血病(CML)区分开来。目前报道的aCML发病率并不准确,因为aCML主要基于形态学特征和其他未明确的实验室检查结果进行诊断,而且aCML及其他MDS/MPN疾病的漏诊几率特别高。下一代测序(NGS)的最新进展使人们对aCML的本质有了更深入的了解,为提高诊断准确性以及使用更具针对性的治疗以取得更好疗效提供了更好的机会。在此,我们报告一例68岁女性患者,她因气短、乏力和虚弱前来我院就诊,检查发现白细胞显著增多、肝脾肿大,且Ph染色体阴性。NGS进一步检查发现ASXL1、GATA2、NRAS和SRSF2基因发生突变,但CSF3R未发生突变。除此之外,基于特定的形态学检查结果,外周血涂片和骨髓穿刺检查结果提示为aCML。由于该患者不符合干细胞移植(SCT)条件,故开始采用细胞输注进行对症治疗;然而,患者仍持续存在症状性贫血,需要多次输血。后来基于她的一种基因突变,开始使用丝裂原活化蛋白激酶激酶(MEK)抑制剂曲美替尼进行靶向治疗试验。有趣的是,患者的血细胞计数稳定,她感觉状况好转,并且在使用曲美替尼治疗期间连续四个月无需输血。不幸的是,我们的患者后来死于继发感染引起的败血症。鉴于NGS取得的重大进展,临床医生应始终考虑将其作为一种有用的工具,不仅用于确诊罕见的aCML,而且在适用时提供最佳的靶向治疗。这可能减轻与aCML预后不良相关的负担。